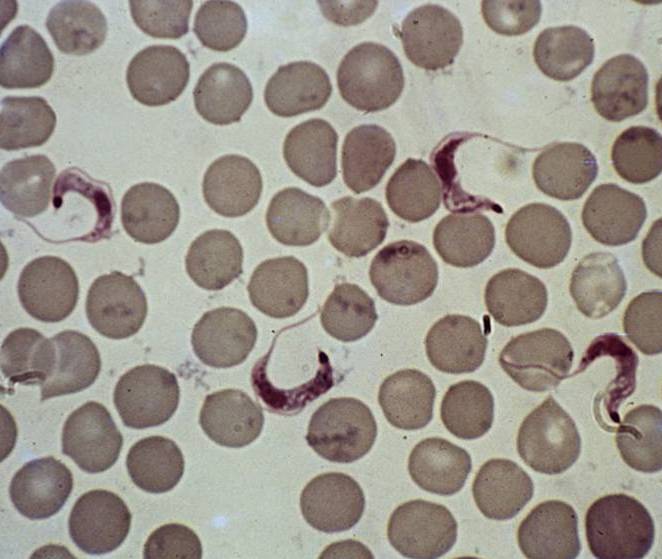

La malaltia de Chagas, també anomenada tripanosomiasi americana, és una malaltia potencialment mortal causada pel paràsit protozou Trypanosoma cruzi. Es troba sobretot en zones endèmiques de 21 països d’Amèrica Llatina, on es transmet als éssers humans principalment pel contacte amb la femta d’insectes triatomins coneguts com xinxes o amb altres noms, segons la zona geogràfica.
Altres vies de transmissió són transfusions de sang infectada, transplantaments d’òrgans provinents d’una persona infectada, la congènita, de mare infectada a fill durant l’embaràs o el part o per accident de laboratori.
Es calcula que al món hi ha entre 6 i 7 milions de persones infectades, la majoria d’elles a l’Amèrica Llatina, on la malaltia de Chagas és endèmica. El cost del tractament d’aquesta malaltia segueix sent considerable; només a Colòmbia, el cost anual estimat el 2008 de l’atenció mèdica a tots els pacients fou d’aproximadament US $ 267 milions. D’altra banda, la fumigació amb insecticides per interrompre la transmissió a través dels vectors costaria prop de US $ 5 milions a l’any.
La infecció pel paràsit típicament afecta el cor i/o sistema digestiu d’adults joves, de forma crònica, i ha estat i és, conseqüentment, un dels majors problemes de salut pública, amb greus conseqüències socioeconòmiques, per les famílies i estats afectats.
Existeixen medicaments eficaços si s’administren al començament de la infecció, no obstant, l’eficàcia disminueix a mesura que transcórrer el temps des de l’inici de la infecció.
No hi ha vacuna, i a Amèrica Llatina el mètode mes eficaç de prevenció és el control de l’insecte transmissor. A tots els països afectats el cribatge de la sang és necessari per prevenir la infecció per transfusions sanguínies i donació d’òrgans.
La malaltia és originària del continent Americà, però progressivament s’ha detectat en altres continents. Actualment la majoria de persones infectades es troben als 21 països d’Amèrica Llatina (de Mèxic fins al sud: Xile i Argentina), però també es presenta de manera no endèmica a països com els Estats Units d’Amèrica, Canadà, Austràlia, Japó i a 17 països europeus, incloent també L’Estat Espanyol, on s’estima que hi pot haver almenys 60.000-80.000 casos.
Coneixeu millor la malaltia visitant la web de l’OMS.
Imatge encapçalament: Coura. Lab. Doenças Parasitárias, IOC-Fiocruz